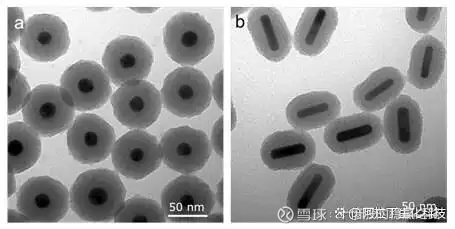

阿拉丁 科创万金油(黄金产品)

今天实在有点忍不住了,随随便便涉及黄金的都涨停了。
做饰品的黄金涨价应该是利空,也涨停。
那么不得不搬出阿拉丁的纳米金产品了。
写这篇文章,纯属发泄,对于狂热的追捧一向不感冒。
1、aladdin 阿拉丁 G112793 纳米金粉 7440-57-5 ≥99.9% metals basis, ≤500 nm
中文名称:金纳米棒英文名称:Gold NanorodsCAS:7440-57-5品牌:阿拉丁产地:上海保存条件:2-8°C储存,充氩纯度规格:10 nm diameter, λmax, 780 nm, dispersion in H2O产品类别:材料科学 电子材料分子式:Au分子量:196.97MDL:MFCD00003436运输条件:低温运输产品规格:5ml货号:G359095是否进口:否
中文名:金纳米棒
英文名:Gold Nanorods
纯度:10 nm diameter, λmax, 780 nm, dispersion in H2O
货号:G359095
Cas号:7440-57-5
存储温度:2-8°C储存,充氩
运输条件:低温运输
2、金纳米粒子
级别和纯度: 直径15 nm,OD 1,柠檬酸盐缓冲液悬浮液
MDL号: MFCD00003436
货号 (SKU)包装规格是否现货价格数量G486034-25ml
25ml期货
原价: ¥959.90
G486034-100ml
100ml期货
原价: ¥2,879.90
3、Aladdin/阿拉丁 金纳米粒子 0.5ml, 直径30nm,生物素封端,PEG 5000,外径50,在H₂O中分散
货号: 4178698
品牌: Aladdin/阿拉丁
规格: 0.5ml, 直径30nm,生物素封端,PEG 5000,外径50,在H₂O中分散
编码: G486069-0.5ml
价格:¥ 3,173.00 / 瓶
相关论文如下:
《阿拉丁-二氧化硅包覆金纳米颗粒:表面化学、性质、效益和应用》

2023-10-30 11:09上海
关注

引言
在过去的几十年里,金纳米颗粒的研究和商业应用已经迅速扩展到从生物医学工程[1]到光伏发电[2]的各个领域。大多数应用都利用了金纳米粒子优异的光学特性,这种特性可以通过改变它们的形状和大小来进行微调。
然而,未涂覆的金纳米颗粒在溶液中容易聚集,并且在激光照射下会熔化,这两种情况都会导致其光学性能发生显著变化。当它们的表面通过化学官能化进行适当钝化时,它们可以在广泛的生物、物理和环境条件下抵抗聚集和形状变化,从而使其光学性质得以保存。其中一种已被证明可以增强金纳米颗粒热力学和化学稳定性的强大功能化方法是二氧化硅涂层[1,3,4]。二氧化硅涂层所赋予的优异稳定性和功能性使其成为以下所述许多应用的首选。二氧化硅包覆金纳米球和纳米棒的示例如图1所示。
图 1 :(a)二氧化硅包覆金纳米球的SEM图和(b)二氧化硅包覆金纳米棒的SEM图
二氧化硅包覆金纳米颗粒材料的表面化学与合成
二氧化硅包覆金纳米颗粒是使用经典的Stöber方法完成的,该方法涉及正硅酸四乙酯(TEOS),在金表面形成高度支化和介孔的硅氧烷聚合物。该反应可以被控制,从而可以根据反应时间和试剂浓度来定制金表面二氧化硅层的厚度。生成的表面硅氧烷聚合物(称为二氧化硅)具有羟基(-OH)基团,可以用作进一步功能化的基础。此外,杂双功能硅烷连接剂很容易与二氧化硅反应,提供了一种将各种配体(如聚乙二醇(PEG))附着到二氧化硅表面的方法(图 2)。

图 2:二氧化硅包覆金纳米粒子的表面化学性质。显示了一个带有羟基官能团的裸露二氧化硅表面(左)和一个可以被不同端基功能化的聚乙二醇(PEG)包覆的纳米粒子,包括胺、硫醇、马来酰亚胺和n -羟基琥珀酰亚胺等。
二氧化硅包覆金纳米颗粒的性质和优势
纳米金颗粒的二氧化硅涂层在许多涉及金纳米颗粒的应用中是有利的。特别是在脉冲激光器的应用中,二氧化硅涂层极大地增强了金纳米棒的热力学稳定性。具有标准涂层(如PEG、CTAB或其他小聚合物)的金纳米棒可以从脉冲激光中吸收足够的能量以熔化(图 3)。这种形状的变化导致其吸收和散射光的相应变化,从近红外波长到可见光谱对于一致的近红外光吸收至关重要的应用,具有二氧化硅涂层的金纳米棒可以抵抗形状变化,并且可以在更高的光强水平下保持其光学特性(图 4)。

图 3:金纳米棒以及其光学特性在脉冲激光曝光前(左)和曝光后(右)。没有二氧化硅涂层的标准金纳米棒非常不稳定,会响应激光吸收而熔化,降低其对近红外波长光的吸收和散射。

图 4:暴露于不同强度(fluence)的300次808 nm光脉冲后,二氧化硅涂层金纳米棒的吸光度谱。二氧化硅包覆的颗粒在高达20 mJ/cm2的影响下具有热力学稳定性(它们抵抗形状变化)。
除了热力学稳定性(抗熔融)和胶体稳定性外,金纳米棒的二氧化硅涂层还具有其他显着的性能和优势。例如,二氧化硅涂层增加了抗体或其他靶向部分偶联的表面积。此外,二氧化硅是多孔的,可以通过物理吸附或共价附着来装载药物、染料分子或其他显像剂。二氧化硅涂层还限制了纳米棒在高浓度下的包装紧密程度,边缘化了等离子体耦合的影响,并允许不受浓度影响的光学性质的保存。最后,金纳米颗粒上的二氧化硅涂层可以将成像对比度提高3倍以上[1]。
在光声成像中聚乙二醇化的二氧化硅包覆的金纳米颗粒(图 2 -右)可以提供二氧化硅包覆的所有好处,以及与聚乙二醇包覆的纳米颗粒相关的性能,包括更高的胶体稳定性和更低的免疫原性。
二氧化硅包覆金纳米结构的应用
1. 光声成像
当用作光声成像(光声成像)中的造影剂时,金纳米棒吸收来自脉冲激光的光并产生大量热量。虽然光声效应需要这种热量,但热量过多也不合适,会导致纳米棒熔化(图 2)。这种形状变化导致吸收横截面减少,从而导致光声成像对比度损失。二氧化硅涂层有助于降低金与周围溶剂之间的界面热阻(图 5),允许颗粒向其环境释放更多的热量,这有两个积极的影响:(1)金颗粒可以在高通量下抵抗熔化(图 3),(2)这些颗粒产生的光声信号至少比具有PEG,CTAB或其他小聚合物等标准涂层的金纳米颗粒大3倍的热力学稳定性[1]。
热力学稳定的硅包覆金纳米棒和纳米球由于其优越的热力学稳定性、光学特性、生物相容性和生物偶联潜力,已成为光声造影剂和治疗剂的热门选择[1]。

图 5:从纳米颗粒到环境的热传输过程的示意图,以及由此产生的纳米颗粒表面附近温度(T)和远离表面的光声信号(P)的振幅的时间分布。(a)具有高界面电阻的裸纳米颗粒导致温度分布变宽和光声压力信号的振幅变小;(b)引入硅壳使得金(Au)与SiO2、SiO2与水之间的界面阻力最小。由此产生的更尖锐的温度剖面,并且由于温度剖面在更大的距离上,光声信号增加;(c)厚壳导致温度峰变宽,光声信号再次下降,尽管它可能仍然高于裸纳米颗粒。
2. 细胞跟踪
由于光声成像(光声成像)是非侵入性的、定量的,并且扫描时间短,因此它是与超声成像结合进行免疫细胞跟踪[8]和干细胞植入跟踪[10]的理想工具(图 6)。二氧化硅涂层金纳米棒可以用作光声成像中的造影剂,实时量化植入细胞,并确认足够数量的细胞已到达治疗部位。二氧化硅涂层还有助于促进金纳米棒的细胞摄取[8]。

图 6:第一张图显示SiO2-AuNRs(二氧化硅涂层金纳米棒)的TEM图像,峰值吸收676 nm,二氧化硅涂层厚度20 nm,第二张图证实了注射到活小鼠肌肉组织后间充质干细胞内存在SiO2-AuNRs;第三张图显示了胸腺发育小鼠后肢肌肉注射SiO2-AuNRs标记间充质干细胞的对比增强光声图像。
二氧化硅涂层金纳米棒由于体积小,在红光和近红外光谱中具有可调谐的共振, 并且具有非常高的吸收截面,因此也广泛用于光热治疗。二氧化硅涂层增加了金纳米棒的光热稳定性,从而有助于在高连续和脉冲激光通量下保持其优越的光学性能[1,3,6]。二氧化硅涂层的金纳米棒也显示出比PEG涂层的金纳米棒显著增加细胞摄取,这反过来转化为更好的光热消融效果[10]。此外,二氧化硅涂层纳米棒可以与光声成像结合使用,同时创建光热治疗过程中的热生成图,可以指导其剂量和治疗效果[7]。
3. 靶向给药
二氧化硅涂层的金纳米颗粒具有生物相容性,可以进行化学修饰,专门针对癌组织。介孔二氧化硅包覆的金纳米颗粒由于其表面积大、尺寸可调、高可达孔体积、载药能力和明确定义的表面特性使化学修饰成为可能(图 4)。与光热疗法和单独化疗相比,载药二氧化硅包覆金纳米棒完成的联合化学光热疗法已被证明具有增强的抗癌效果[11]。
4. 多路图像
靶向二氧化硅包被的金纳米棒可以作为造影剂用于多重成像,通过将纳米颗粒靶向表达不同细胞受体的细胞来区分体外细胞包裹体[12](图7)。具有不同峰值波长的二氧化硅涂层金纳米棒可以用于标记每种独特的细胞类型,以确定特定细胞类型的位置,并生成与分子表达相对应的图像。

图 7:对细胞幻影光声(PA)图像进行信号处理和统计分析,证实了细胞内含物的独特识别:a)在超声图像中可以看到内含物;b)在830 nm处获得的PA图像显示了包裹体中含有硅包覆的金纳米棒(SiO2-AuNR);c)PA信号强度(点)和UV-VIS光谱(实线)的对比表明,SiO2-AuNR光吸收光谱决定了PA信号强度。将包裹体分割成三个区域,取PA信号强度的平均值;d)细胞分子图谱和US覆盖;830 nm二氧化硅涂层金纳米棒用红色表示,780 nm SiO2-AuNR用黄色表示。
5. 双模式/多模式成像
虽然光学成像技术具有很高的灵敏度,可以以优异的分辨率可视化病变组织,但它们受到光在组织中的低穿透性的限制。使用互补成像方式的组合可以帮助优化灵敏度和特异性。例如,同时增强CT对比度和近红外光学成像的造影剂可以提供不同水平造影剂积累的可量化信息。负载有机NIR染料(如吲哚菁绿(ICG))的介孔硅包覆金纳米棒可以用作双模X射线CT和NIR荧光成像的成像探针[13]。

图 8:(a)瘤内注射负载吲哚菁绿的二氧化硅包覆金纳米棒(200μL, 1.5 mg/mL)前和12 h后小鼠体内平面X射线图像(曝光时间30 s);(b)瘤内注射双模成像造影剂12 h后60 s曝光时间(左)的体内平面X射线图像与对应的近红外荧光图像(10 s曝光时间)(右)重叠。插图:亮场与近红外荧光图像的对应叠加。绿色箭头表示肿瘤。夹在金纳米棒和吲哚菁绿发色团之间的薄层二氧化硅保护染料免受荧光猝灭。
6. 表面增强拉曼光谱(SERS)
染料嵌入的二氧化硅包覆金纳米颗粒对表面拉曼增强非常有效,可以用作多路检测和光谱标记颗粒[14]。光信号增强的金属核、用于光谱标记的特征分子由二氧化硅外壳组成。

图 9:核-壳纳米颗粒结构示意图和制备二氧化硅包覆SERS活性金胶体的过程。(a)在632 ~ 647 nm波长的光激发下,对表面拉曼增强优化的胶体金颗粒尺寸范围为55 ~ 65nm;(b)具有吸附拉曼报告因子的金颗粒;(c)同时含有报告剂和巯基丙基三甲氧基硅烷(一种常见的偶联剂)的金颗粒;(d)在核壳边界嵌入拉曼光谱报告器的二氧化硅涂层金颗粒。
二氧化硅涂层的金纳米棒也被用作靶向癌细胞的双模成像探针。荧光和表面增强拉曼散射信号可以通过不同的纳米粒子激发波长独立显示[17]。
7. 双光子成像
包含光敏剂如Pd -介孔四(4-羧基苯基)卟啉(PdTPPs)的介孔硅涂层金纳米棒可用于双光子激活的光动力治疗(图 10)[16] 。将光敏剂掺杂到介孔二氧化硅外壳的纳米通道中,可以通过包裹的双光子激发金纳米棒的粒子内等离子共振能量转移来激发光敏剂,并可以产生细胞毒性单线态氧来杀死癌细胞。通过提供抗热变形的机械支撑,二氧化硅基体可以显著提高金纳米棒核心的双光子发光稳定性。

图 10:体内研究表明,在肿瘤内注射介孔硅包覆金纳米棒PdTPPs后,进行双光子激活光动力治疗。采用苏木精和伊红(第一行)、TUNEL(第二行,绿色)、Caspase- 3(第三行,红色)和 DAPI(蓝色)染色,对照射24 h后的收获肿瘤切片进行组织学分析。通过细胞凋亡指标TUNEL和Caspase-3染色,观察到介孔硅包覆金纳米线-PdTPPs联合激光照射对肿瘤生长的抑制作用(1.2次,图6i)。
8. 生物分子探针
由于二氧化硅在中红外范围内的高发射率,二氧化硅涂层的金纳米颗粒可以用作
DNA杂交测定的标签,以检测较低的目标DNA浓度,而不是柠檬酸盐涂层或标准金纳米颗粒。基于荧光的DNA杂交和蛋白质结合分析可以使用硅包覆的金纳米颗粒作为不降解,淬灭或光漂白的稳健标记来改进[17]。这种纳米粒子平台也可用于检测极低浓度的蛋白质、细菌、农药和汞等小分子。
9. 催化剂
金纳米颗粒要想成为有效的催化剂,就必须在周围介质、热环境中高度稳定,并在保持催化活性的同时具有回收潜力。通常,金纳米棒表面涂有一种叫做十六烷基三甲基溴化铵(CTAB)的表面活性剂。在有机溶液中,CTAB解吸到介质中会导致金纳米棒聚集并失去其催化性能。此外,CTAB包覆的金纳米棒可能是热力学不稳定的,这可以诱导转化为球形颗粒。介孔二氧化硅包被的金纳米棒作为催化剂是非常有效的,因为二氧化硅外壳在包括热、溶剂交换和离心在内的不利条件下提供了很高的稳定性[18]。由于介孔二氧化硅壳具有较大的孔体积,反应物分子可以通过孔扩散到金表面进行催化。
10. 光子学
等离子体金纳米粒子用于许多光子学应用;这些应用包括单分子检测、光子晶体构建和光学器件设计(如波导)。然而,由于相邻裸金纳米粒子的金属之间的物理接触,阻止了光子带隙的形成。在金纳米粒子上涂上一层光学透明、化学惰性和光化学稳定的材料(如二氧化硅),当等离子体纳米粒子以周期性结构组织时,就可以产生完整的光子带隙[19]。此外,二氧化硅涂层还有助于等离子体荧光增强,因为它抑制了当荧光团直接与金属表面结合时发生的猝灭机制。因此,与标准的金纳米颗粒相比,二氧化硅涂层的金纳米颗粒具有多种优势。
综上所述,二氧化硅涂层的金纳米颗粒可以提供几种有益的特性,包括:
● 在光声成像和其他涉及使用脉冲激光的模式中具有更高的成像信号强度优越的热稳定性和胶体稳定性;
● 稳定的光学特性,适用于更广泛的应用,包括多模态成像治疗能力,便于用作混合药物载体和显像剂;
● 用于共价功能化和偶联的柔性硅烷化学。
这些独特的优势使它们成为许多应用的理想选择。
参考文献
1.Chen Y, Frey W, Kim S, Kruizinga P, Homan K, Emelianov S. 2011. Silica-Coated Gold Nanorods as Photoacoustic Signal Nanoamplifiers. Nano Lett.. 11(2):348-354.
2.Yang J, You J, Chen C, Hsu W, Tan H, Zhang XW, Hong Z, Yang Y. 2011. Plasmonic Polymer Tandem Solar Cell. ACS Nano. 5(8):6210-6217.
3.Chen Y, Frey W, Kim S, Homan K, Kruizinga P, Sokolov K, Emelianov S. 2010. Enhanced thermal stability of silica-coated gold nanorods for photoacoustic imaging and image-guided therapy. Opt. Express. 18(9):8867.
4.Luke GP, Bashyam A, Homan KA, Makhija S, Chen Y, Emelianov SY. 2013. Silica-coated gold nanoplates as stable photoacoustic contrast agents for sentinel lymph node imaging. Nanotechnology. 24(45):455101.
5.Zijlstra P, Chon JWM, Gu M. 2009. Five-dimensional optical recording mediated by surface plasmons in gold nanorods. Nature. 459(7245):410-413.
6.Kim S, Chen Y, Luke GP, Emelianov SY. 2014. In-vivo ultrasound and photoacoustic image- guided photothermal cancer therapy using silica-coated gold nanorods. IEEE Trans. Ultrason., Ferroelect., Freq. Contr.. 61(5):891-897.
7.Chen Y, Frey W, Walker C, Aglyamov S, Emelianov S. 2013. Sensitivity enhanced nanothermal sensors for photoacoustic temperature mapping. J. Biophoton.. 6(6-7):534-542.
8.Joshi PP, Yoon SJ, Chen Y, Emelianov S, Sokolov KV. 2013. Development and optimization of near-IR contrast agents for immune cell tracking. Biomed. Opt. Express. 4(11):2609.
9.Jokerst JV, Thangaraj M, Kempen PJ, Sinclair R, Gambhir SS. 2012. Photoacoustic Imaging of Mesenchymal Stem Cells in Living Mice via Silica-Coated Gold Nanorods. ACS Nano. 6(7):5920-5930.
10.Zhu X, Fang C, Jia H, Huang Y, Cheng CHK, Ko C, Chen Z, Wang J, Wang YJ. Cellular uptake behaviour, photothermal therapy performance, and cytotoxicity of gold nanorods with various coatings. Nanoscale. 6(19):11462-11472.
11.Monem AS, Elbialy N, Mohamed N. 2014. Mesoporous silica coated gold nanorods loaded doxorubicin for combined chemo?photothermal therapy. International Journal of Pharmaceutics. 470(1-2):1-7.
12.Bayer CL, Chen Y, Kim S, Mallidi S, Sokolov K, Emelianov S. 2011. Multiplex photoacoustic molecular imaging using targeted silica-coated gold nanorods. Biomed. Opt. Express. 2(7):1828.
13.Luo T, Huang P, Gao G, Shen G, Fu S, Cui D, Zhou C, Ren Q. 2011. Mesoporous silica-coated gold nanorods with embedded indocyanine green for dual mode X-ray CT and NIR fluorescence imaging. Opt. Express. 19(18):17030.
14.Doering WE, Nie S. 2003. Spectroscopic Tags Using Dye-Embedded Nanoparticles and Surface-Enhanced Raman Scattering. Anal. Chem.. 75(22):6171-6176.
15.Wang Z, Zong S, Yang J, Li J, Cui Y. 2011. Dual-mode probe based on mesoporous silica coated gold nanorods for targeting cancer cells. Biosensors and Bioelectronics. 26(6):2883-2889.
16.Chen N, Tang K, Chung M, Cheng S, Huang C, Chu C, Chou P, Souris JS, Chen C, Mou C, et al. 2014. Enhanced Plasmonic Resonance Energy Transfer in Mesoporous Silica-Encased Gold Nanorod for Two-Photon-Activated Photodynamic Therapy. Theranostics. 4(8):798-807.
17.Xia F, Zuo X, Yang R, Xiao Y, Kang D, Vallee-Belisle A, Gong X, Yuen JD, Hsu BBY, Heeger AJ, et al. 2010. Colorimetric detection of DNA, small molecules, proteins, and ions using unmodified gold nanoparticles and conjugated polyelectrolytes. Proceedings of the National Academy of Sciences. 107(24):10837-10841.
18.Son M, Lee J, Jang D. 2014. Light-treated silica-coated gold nanorods having highly enhanced catalytic performances and reusability. Journal of Molecular Catalysis A: Chemical. 38538-45.
19.Rodríguez-Fernández J, Pastoriza-Santos I, Pérez-Juste J, García de Abajo FJ, Liz-Marzán LM. 2007. The Effect of Silica Coating on the Optical Response of Sub-micrometer Gold Spheres. J. Phys. Chem. C. 111(36):13361-13366.